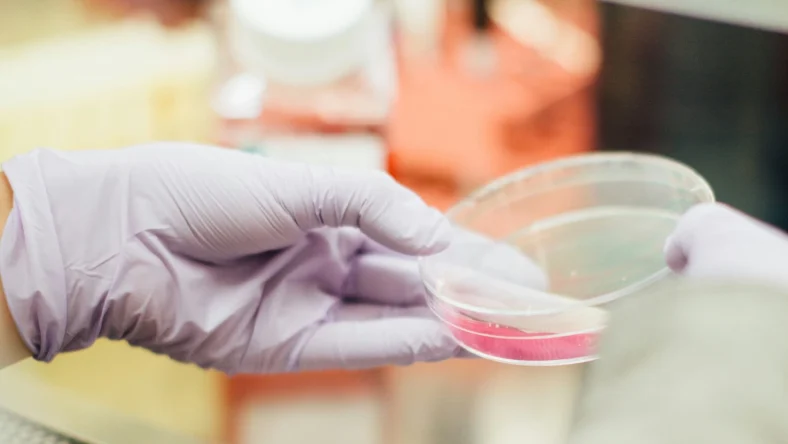
person in lab with plastic container

Discovery offers new Insights into fat burning and obesity prevention
Researchers from ETH Zurich, in collaboration with several international institutions, have identified a new type of beige fat cell that may revolutionize the understanding and treatment of obesity and metabolic diseases like diabetes.
This discovery, led by Professor Christian Wolfrum’s group at ETH Zurich, sheds light on how these fat cells, which are found in almost all humans, contribute to energy metabolism and overall health. The findings could help personal trainers inform their approaches to designing wellness programs.
Beige Fat Cells: A New Hope in Metabolic Health
Fat cells have traditionally been categorized into three types: white, brown, and beige. While white fat cells store energy and brown fat cells generate heat, beige fat cells have been known to consume energy and produce heat, albeit less effectively than their brown counterparts. These beige cells are typically scattered throughout white adipose tissue in adults, particularly in the neck and shoulder regions, where they help regulate energy use.
The newly discovered class of beige fat cells functions differently from the previously known ones. Unlike the classic beige cells that produce heat through a protein called UCP1, the new cells utilize a process the researchers have dubbed the “Sisyphus mechanism.”
This process involves seemingly futile biochemical cycles that break down fats and then immediately reconstruct them, or convert creatine into creatine phosphate and back again, generating heat and consuming energy without producing a net biochemical gain.
Applications for Program Design
This discovery presents a potential new avenue for developing more effective weight management and metabolic health strategies for clients. By understanding the role of beige fat cells in energy metabolism, trainers and coaches can design exercise programs and nutrition plans aimed at activating these cells. This could enhance clients’ fat-burning capabilities and improve overall metabolic health, making fitness regimens more tailored and effective.
The research team first observed these new beige fat cells in mice and then confirmed their presence in human adipose tissue. Notably, while fewer than half of the population has the classic type of beige fat cells, almost everyone has this new type, though in varying amounts. Importantly, individuals with a higher number of these cells tend to be slimmer and have better metabolic health, making them less susceptible to obesity and related disorders.
“These beige fat cells play a crucial role in converting excess energy into heat, which helps in breaking down fat and improving overall metabolic health,” said Anand Sharma, a postdoctoral researcher in Wolfrum’s group and coauthor of the study. “Understanding how these cells work could open up new avenues for treating metabolic diseases.”
Future Medical Applications
The discovery could lead to significant advancements in medical treatments for obesity and diabetes. Potential applications include transplanting these beige fat cells into individuals with metabolic disorders or developing drugs to activate these cells in people where they are inactive. Such treatments could assist in maintaining lower body weight or managing high blood sugar levels, particularly in patients who have lost weight through surgery or other interventions.
“Activating beige fat cells could be a game-changer in helping people maintain a healthier body weight and reducing the risk of metabolic diseases,” said Tongtong Wang, an ETH doctoral student and lead author of the study.